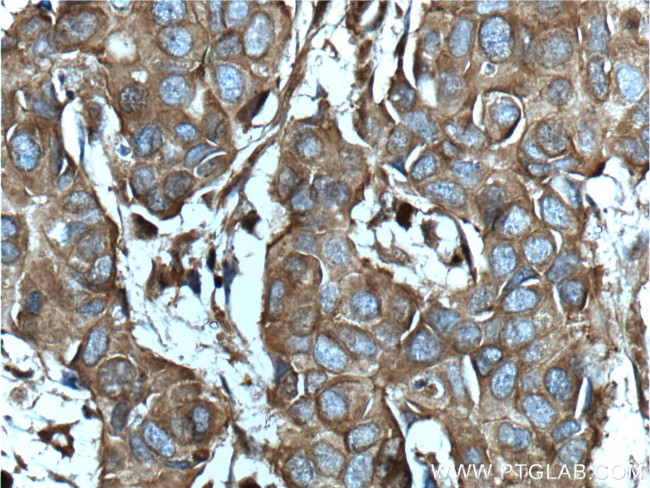
CD46 Antibody in Immunohistochemistry (Paraffin) (IHC (P))
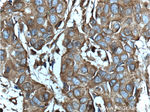
CD46 Antibody in Immunohistochemistry (Paraffin) (IHC (P))

Search
Proteintech
CD46 Polyclonal Antibody
{{$productOrderCtrl.translations['antibody.pdp.commerceCard.promotion.promotions']}}
{{$productOrderCtrl.translations['antibody.pdp.commerceCard.promotion.viewpromo']}}
{{$productOrderCtrl.translations['antibody.pdp.commerceCard.promotion.promocode']}}: {{promo.promoCode}} {{promo.promoTitle}} {{promo.promoDescription}}. {{$productOrderCtrl.translations['antibody.pdp.commerceCard.promotion.learnmore']}}
产品信息
12494-1-AP
种属反应
已发表种属
宿主/亚型
分类
类型
抗原
偶联物
形式
浓度
规格
纯化类型
保存液
内含物
保存条件
运输条件
产品详细信息
Immunogen sequence: PPTFEAMEL IGKPKPYYEI GERVDYKCKK GYFYIPPLAT HTICDRNHTW LPVSDDACYR ETCPYIRDPL NGQAVPANGT YEFGYQMHFI CNEGYYLIGE EILYCELKGS VAIWSGKPPI CEKVLCTPPP KIKNGKHTFS EVEVFEYLDA VTYSCDPAPG PDPFSLIGES TIYCGDNSVW SRAAPECKVV KCRFPVVENG KQISGFGKKF YYKATVMFEC DKGFYLDGSD TIVCDSNSTW DPPVPKCLKV STSSTTKSPA SSASGPRPTY KPPVSNYPGY PKPEEGILDS LDVWVIAVIV IAIV (38-340 aa encoded by BC030594)
靶标信息
CD46 (MCP, membrane cofactor protein) is a multifunctional cell surface transmembrane protein that binds and inactivates C3b and C4b complement fragments, regulates T cell-induced inflammatory responses by either inhibiting (CD46-1 isoform) or increasing (CD46-2 isoform) the contact hypersensitivity reaction. CD46 also serves as a receptor for several human pathogens (both bacteria and viruses), and its ligation alteres T lymphocyte polarization toward antigen-presenting cells or target cells, inhibiting lymphocyte function. CD46 is a protector of placental tissue and is also expressed on the inner acrosomal membrane of spermatozoa.
仅用于科研。不用于诊断过程。未经明确授权不得转售。
生物信息学
蛋白别名: antigen identified by monoclonal antibody TRA-2-10; CD46; CD46 antigen, complement regulatory protein; CD46 molecule, complement regulatory protein; complement membrane cofactor protein; measles virus receptor; Membrane cofactor protein; membrane cofactor protein (CD46, trophoblast-lymphocyte cross-reactive antigen); MGC26544; TLX; trophoblast leucocyte common antigen; Trophoblast leukocyte common antigen; trophoblast-lymphocyte cross-reactive antigen; unnamed protein product
基因别名: AHUS2; CD46; MCP; MIC10; TLX; TRA2.10
UniProt ID: (Human) P15529, (Mouse) O88174
Entrez Gene ID: (Human) 4179, (Mouse) 17221